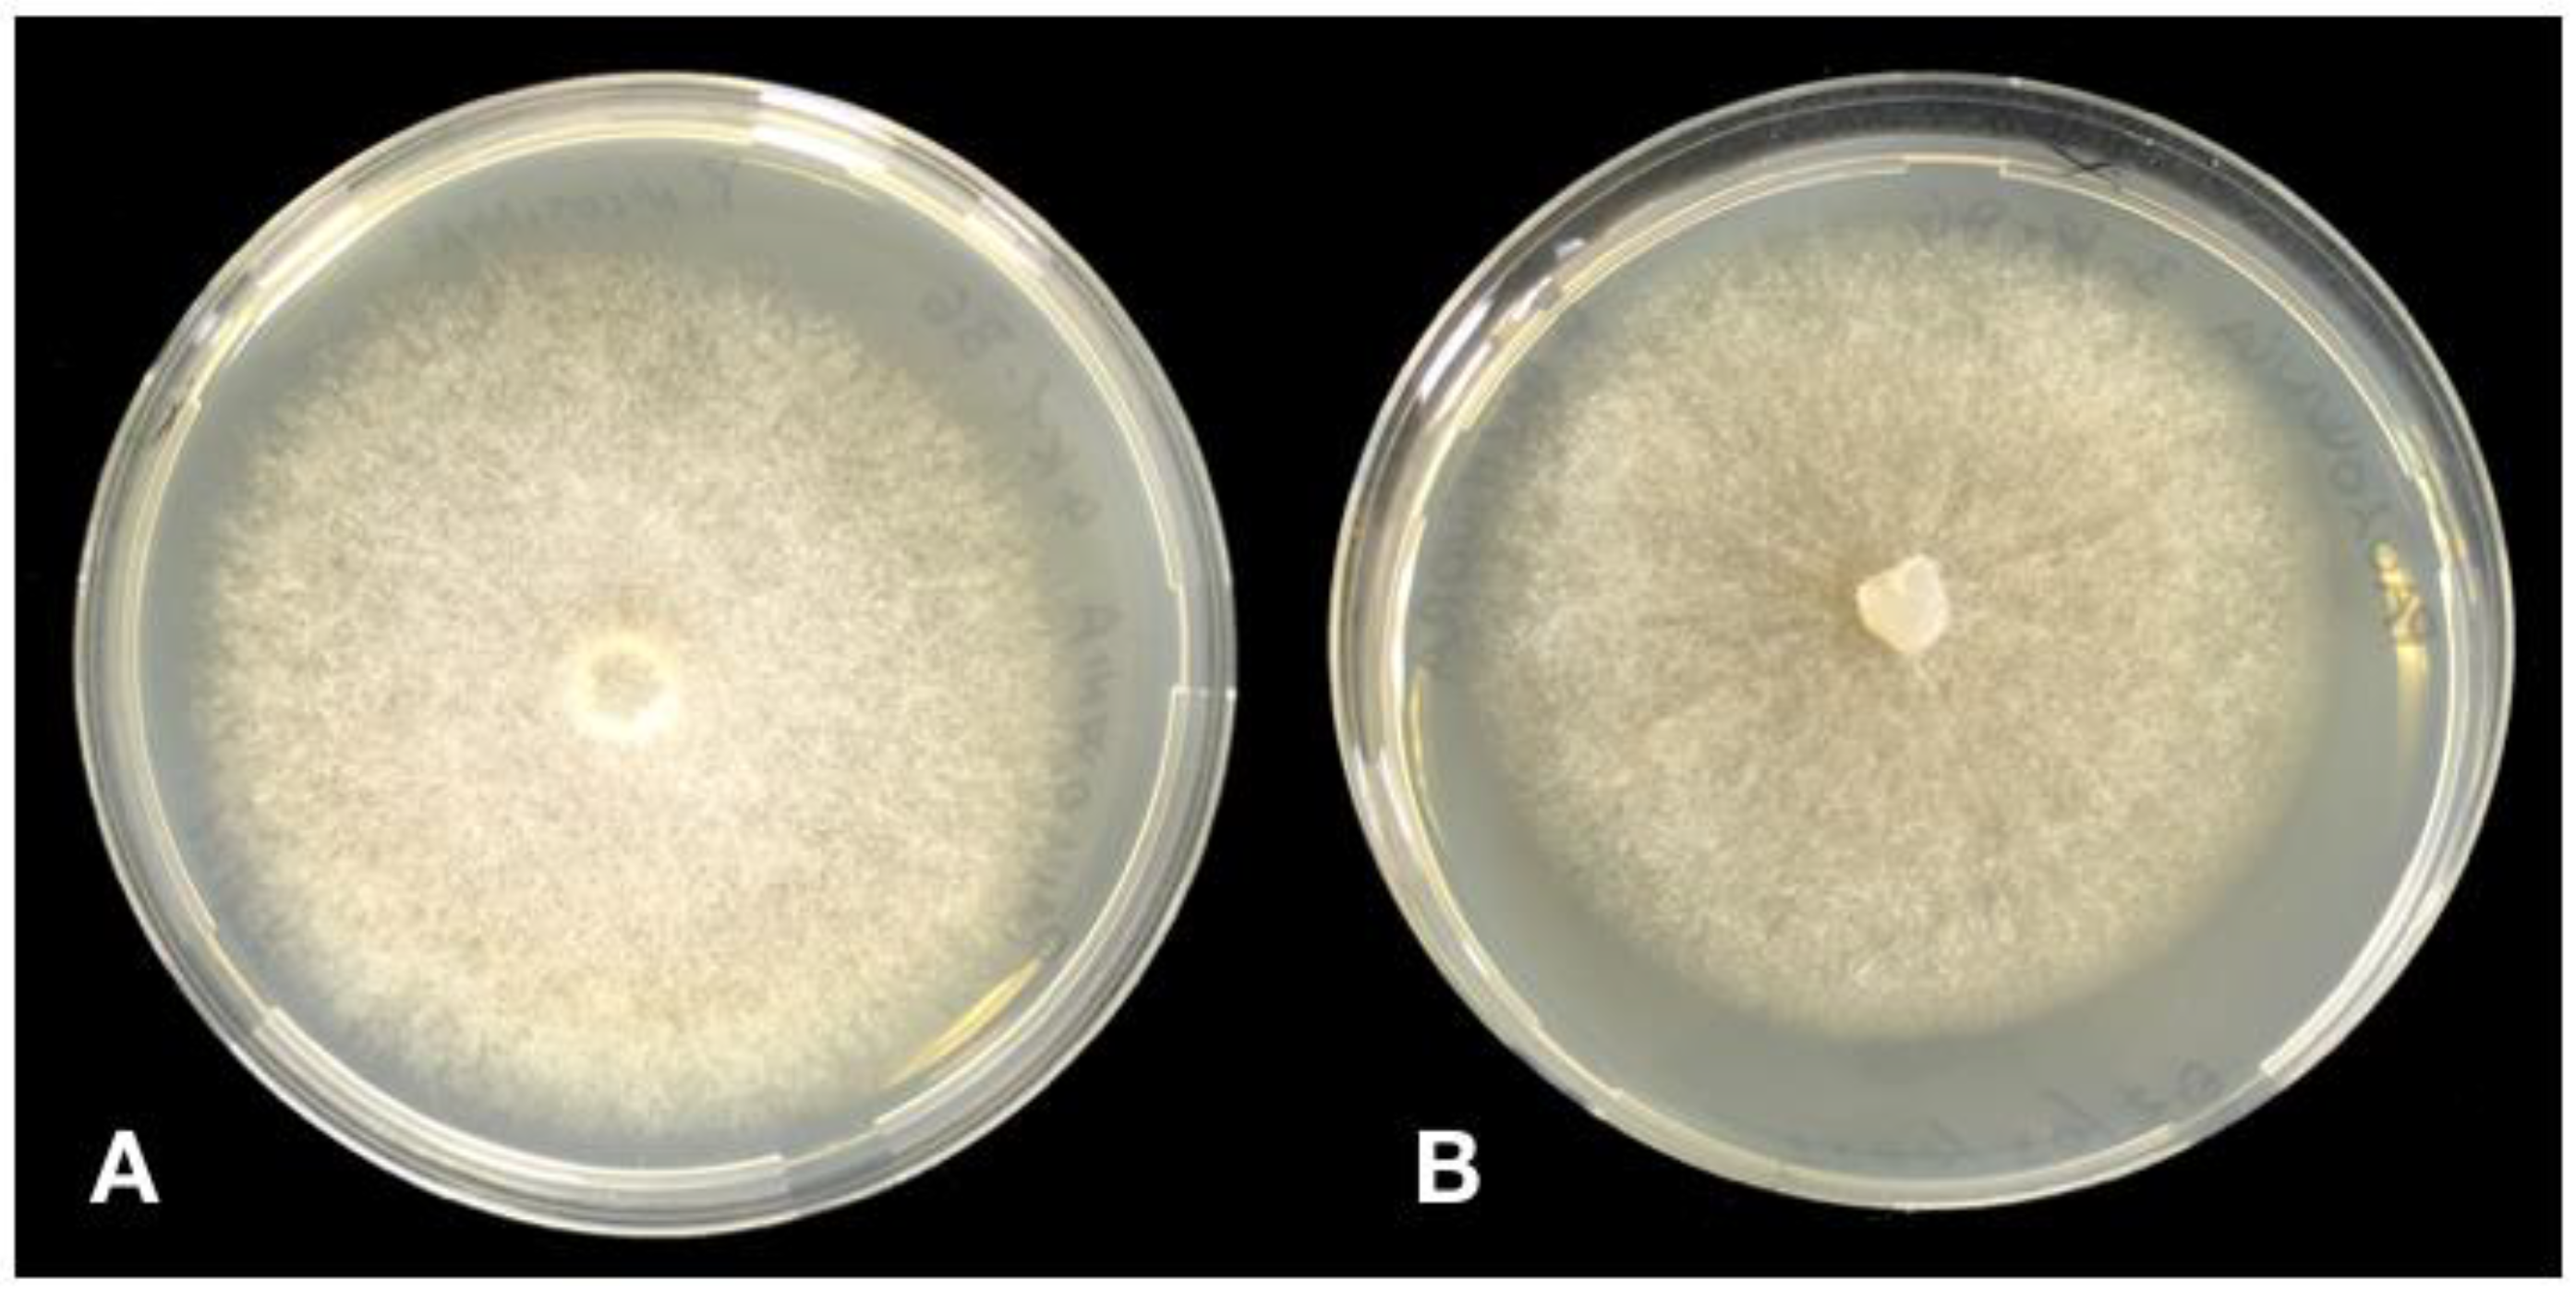
Forests 12 01664 g004

Phytophthora Root and Collar Rot of Paulownia, a New Disease for Europe
Abstract
:1. Introduction
2. Materials and Methods
2.1. Isolation and Morphological Identification of Isolates
2.2. Molecular Identification of Isolates
2.3. Pathogenicity Tests
3. Results
3.1. Symptoms of the Disease
3.2. Morphological Characterisitcs of Phytophthora Isolates
3.3. Molecular Identification
3.4. Pathogenicity Test
4. Discussion
Author Contributions
Funding
Acknowledgments
Conflicts of Interest
References
- Chase, M.W.; Christenhusz, M.J.M.; Fay, M.F.; Byng, J.W.; Judd, W.S.; Soltis, D.E.; Mabberley, D.J.; Sennikov, A.N.; Soltis, P.S.; Stevens, P.F.; et al. An update of the Angiosperm Phylogeny Group classification for the orders and families of flowering plants: APG IV. Bot. J. Linn. Soc. 2016, 181, 1–20. [Google Scholar]
- Toshiyuki, N.; DuVal, A.; Schmull, M.; Tchernaja, T.A.; Crane, P.R. Paulownia tomentosa: A Chineseplant in Japan. Curti’s Bot. Mag. 2013, 30, 261–274. [Google Scholar]
- Bergmann, B.A. Five years of Paulownia field trials in North Carolina. New For. 2003, 25, 185–199. [Google Scholar] [CrossRef]
- Pasiecznick, N. Paulownia tomentosa. Invasive Species Compendium; CABI International: Wallingford, UK, 2019; Available online: www.cabi.org/isc (accessed on 19 August 2021).
- Snow, W.A. Ornamental, crop, or invasive? The history of the Empress tree (Paulownia) in the USA. For. Trees Livelihoods 2015, 24, 85–96. [Google Scholar] [CrossRef]
- Global Invasive Species Database. Species Profile Paulownia Tomentosa. 2021. Available online: http://www.iucngisd.org/gisd/speciesname/Paulownia+tomentosa (accessed on 25 November 2021).
- Essl, F. From ornamental to detrimental? The incipient invasion of Central Europe by Paulownia tomentosa. Preslia 2007, 79, 377–389. [Google Scholar]
- Stewart, W.M.; Vaidya, B.N.; Mahapatra, A.K.; Terrill, T.H.; Joshee, N. Potential use of multipurpose Paulownia elongata tree as an animal feed resource. Am. J. Plant Sci. 2018, 9, 1212–1227. [Google Scholar] [CrossRef] [Green Version]
- Ganchev, G.; Ilchev, A.; Koleva, A. Digestibility and energy content of Paulownia (Paulownia elongata S.Y.Hu) leaves. Agric. Sci. Technol. 2019, 11, 307–310. [Google Scholar] [CrossRef]
- Ray, J.D.; Burgess, T.; Malajczuk, N.; Hardy, G.E.S.J. First report of Alternaria blight of Paulownia spp. Australas. Plant Pathol. 2005, 34, 107–109. [Google Scholar] [CrossRef]
- Hsieh, H.J. Study on Paulownia diseases found in Taiwan. Bull. Taiwan For. Res. Inst. 1983, 388, 1–24, (In Chinese with an English Summary). [Google Scholar]
- Erwin, D.C.; Ribeiro, O.K. Phytophthora Diseases Worldwide; American Phytopathological Society (APS Press): St. Paul, MN, USA, 1996. [Google Scholar]
- Milenković, I.; Tomšovský, M.; Karadžić, D.; Veselinović, M. Decline of Paulownia tomentosa caused by Trametes hirsuta in Serbia. Forest Pathol. 2018, 48, e12438. [Google Scholar] [CrossRef]
- Santilli, E.; Riolo, M.; La Spada, F.; Pane, A.; Cacciola, S.O. First report of root rot caused by Phytophthora bilorbang on Olea europaea in Italy. Plants 2020, 9, 826. [Google Scholar] [CrossRef]
- Jung, T.; Blaschke, H.; Neumann, P. Isolation, identification and pathogenicity of Phytophthora species from declining oak stands. Eur. J. For. Pathol. 1996, 26, 253–272. [Google Scholar] [CrossRef]
- Riolo, M.; Aloi, F.; La Spada, F.; Sciandrello, S.; Moricca, S.; Santilli, E.; Pane, A.; Cacciola, S.O. Diversity of Phytophthora communities across different types of mediterranean vegetation in a nature reserve area. Forests 2020, 11, 853. [Google Scholar] [CrossRef]
- Cooke, D.E.; Drenth, A.; Duncan, J.M.; Wagels, G.; Brasier, C.M. A molecular phylogeny of Phytophthora and related oomycetes. Fungal Genet. Biol. 2000, 30, 17–32. [Google Scholar] [CrossRef]
- White, T.J.; Bruns, T.; Lee, S.; Taylor, J.W. Amplification and direct sequencing of fungal ribosomal RNA genes for phylogenetics. In PCR Protocols: A Guide to Methods and Applications; Innis, M.A., Gelfand, D.H., Sninsky, J.J., White, T.J., Eds.; Academic Press Inc.: San Diego, CA, USA, 1990; Volume 18, pp. 315–322. [Google Scholar]
- FinchTV v.1.4.0. Available online: https://digitalworldbiology.com/FinchTV (accessed on 18 May 2020).
- GenBank. Available online: https://www.ncbi.nlm.nih.gov/genbank/ (accessed on 18 May 2020).
- Phytophthora Database. Available online: http://www.phytophthoradb.org/ (accessed on 18 May 2020).
- La Spada, F.; Stracquadanio, C.; Riolo, M.; Pane, A.; Cacciola, S.O. Trichoderma counteracts the challenge of Phytophthora nicotianae infections on tomato by modulating plant defense mechanisms and the expression of crinkler, necrosis-inducing Phytophthora protein 1, and cellulose-binding elicitor lectin pathogenic effectors. Front. Plant Sci. 2020, 11, 1–16. [Google Scholar]
- Aloi, F.; Riolo, M.; Parlascino, R.; Pane, A.; Cacciola, S.O. Bot gummosis of lemon (Citrus × limon) caused by Neofusicoccum parvum. J. Fungi 2021, 7, 294. [Google Scholar] [CrossRef]
- Jung, T.; Jung, M.H.; Cacciola, S.O.; Cech, T.; Bakonyi, J.; Seress, D.; Mosca, S.; Schena, L.; Seddaiu, S.; Pane, A.; et al. Multiple new cryptic pathogenic Phytophthora species from Fagaceae forests in Austria, Italy and Portugal. IMA Fungus 2017, 8, 219–244. [Google Scholar] [CrossRef] [Green Version]
- Cacciola, S.O.; Pennisi, A.M.; Agosteo, G.E.; Magnano di San Lio, G. First Report of Phytophthora palmivora on Grevillea spp. in Italy. Plant Dis. 2003, 87, 1006. [Google Scholar] [CrossRef]
- Cacciola, S.O.; Pane, A.; Faedda, R.; Rizza, C.; Badalà, F.; Magnano di San Lio, G. Bud and root rot of windmill palm (Trachycarpus fortunei) caused by simultaneous infections of Phytophthora palmivora and P. nicotianae in Sicily. Plant Dis. 2011, 95, 769. [Google Scholar] [CrossRef] [PubMed]
- Robideau, G.P.; De Cock, A.W.A.M.; Coffey, M.D.; Voglmayr, H.; Brouwer, H.; Bala, K.; Chitty, D.W.; Désaulniers, N.; Eggertson, Q.A.; Gachon, C.M.M.; et al. DNA barcoding of oomycetes with cytochrome c oxidase subunit I and internal transcribed spacer. Mol. Ecol. Resour. 2011, 11, 1002–1011. [Google Scholar] [CrossRef] [PubMed]
- Migliorini, D.; Ghelardini, L.; Tondini, E.; Luchi, N.; Santini, A. The potential of symptomless potted plants for carrying invasive soilborne plant pathogens. Divers. Distrib. 2015, 21, 1218–1229. [Google Scholar] [CrossRef]
- Van Tri, M.; Van Hoa, N.; Minh Chau, N.; Pane, A.; Faedda, R.; De Patrizio, A.; Schena, L.; Olsson, C.H.B.; Wright, S.A.I.; Ramstedt, M.; et al. Decline of jackfruit (Artocarpus heterophyllus) incited by Phytophthora palmivora in Vietnam. Phytopathol. Mediterr. 2015, 54, 275–280. [Google Scholar]
- Redekar, N.R.; Eberhart, J.L.; Parke, J.L. Diversity of Phytophthora, Pythium, and Phytopythium species in recycled irrigation water in a container nursery. Phytobiomes J. 2019, 3, 31–45. [Google Scholar] [CrossRef] [Green Version]
- Scanu, B.; Jung, T.; Masigol, H.; Linaldeddu, B.T.; Jung, M.H.; Brandano, A.; Mostowfizadeh-Ghalamfarsa, R.; Janoušek, J.; Riolo, M.; Cacciola, S.O. Phytophthora heterospora sp. nov., a new pseudoconidia-producing sister species of P. palmivora. J. Fungi 2021, 7, 870. [Google Scholar] [CrossRef]
- Graham, J.H.; Bright, D.B.; McCoy, C.W. Phytophthora-Diaprepes weevil complex: Phytophthora spp. relationship with citrus rootstocks. Plant Dis. 2003, 87, 85–90. [Google Scholar] [CrossRef] [Green Version]
- Lo Giudice, V.; Raudino, F.; Magnano di San Lio, R.; Cacciola, S.O.; Faedda, R.; Pane, A. First report of a decline and wilt of young olive trees caused by simultaneous infections of Verticillium dahliae and Phytophthora palmivora in Sicily. Plant Dis. 2010, 94, 1372. [Google Scholar] [CrossRef]
- Pane, A.; Cacciola, S.O.; Scibetta, S.; Bentivenga, G.; Magnano di San Lio, G. Four Phytophthora species causing foot and root rot of apricot in Italy. Plant Dis. 2009, 93, 844. [Google Scholar] [CrossRef]
- Pane, A.; Faedda, R.; Cacciola, S.O.; Rizza, C.; Scibetta, S.; Magnano di San Lio, G. Root and basal stem rot of mandevillas caused by Phytophthora spp. in Eastern Sicily. Plant Dis. 2010, 94, 1374. [Google Scholar] [CrossRef]
- Puglisi, I.; De Patrizio, A.; Schena, L.; Jung, T.; Evoli, M.; Pane, A.; Van Hoa, N.; Van Tri, M.; Wright, S.; Ramstedt, M.; et al. Two previously unknown Phytophthora species associated with brown rot of Pomelo (Citrus grandis) fruits in Vietnam. PLoS ONE 2017, 12, e0172085. [Google Scholar] [CrossRef] [PubMed] [Green Version]
- Aloi, F.; Zamora-Ballesteros, C.; Martín-García, J.; Diez, J.J.; Cacciola, S.O. Co-Infections by Fusarium circinatum and Phytophthora spp. on Pinus radiata: Complex Phenotypic and Molecular Interactions. Plants 2021, 10, 1976. [Google Scholar] [CrossRef]
- Elvira-Recuenco, M.; Cacciola, S.O.; Sanz-Ros, A.V.; Garbelotto, M.; Aguayo, J.; Solla, A.; Mullett, M.; Drenkhan, T.; Oskay, F.; Aday Kaya, A.G.; et al. Potential interactions between invasive Fusarium circinatum and other pine pathogens in Europe. Forests 2020, 11, 7. [Google Scholar] [CrossRef] [Green Version]
- Drenth, A.; Guest, D. Phytophthora palmivora in tropical tree crops. In Phytophthora a Global Perspective; Lamour, K., Ed.; CABI: Oxfordshire, UK, 2013; pp. 187–196. [Google Scholar]
- Kamoun, S.; Furzer, O.; Jones, J.D.G.; Judelson, H.S.; Ali, G.S.; Dalio, R.J.D.; Roy, S.G.; Schena, L.; Zambounis, A.; Panabières, F.; et al. The top 10 oomycete pathogens in molecular plant pathology. Mol. Plant Pathol. 2015, 16, 413–434. [Google Scholar] [CrossRef]
- Biasi, A.; Martin, F.N.; Cacciola, S.O.; Magnano Di San Lio, G.M.; Grünwald, N.J.; Schena, L. Genetic analysis of Phytophthora nicotianae populations from different hosts using microsatellite markers. Phytopathology 2016, 106, 1006–1014. [Google Scholar] [CrossRef] [Green Version]
- Derevnina, L.; Petre, B.; Kellner, R.; Dagdas, Y.F.; Sarowar, M.N.; Giannakopoulou, A.; de la Concepcion, J.C.; Chaparro-Garcia, A.; Pennington, H.G.; van West, P.; et al. Emerging oomycete threats to plants and animals. Philos. Trans. R. Soc. Biol. Sci. 2016, 371, 20150459. [Google Scholar] [CrossRef] [Green Version]
- Panabières, F.; Ali, G.S.; Allagui, M.B.; Dalio, R.J.D.; Gudmestad, N.C.; Kuhn, M.L.; Guha Roy, S.; Schena, L.; Zampounis, A. Phytophthora nicotianae diseases worldwide: New knowledge of a long-recognised pathogen. Phytopathol. Mediterr. 2016, 55, 20–40. [Google Scholar]
- Guo, Y.; Sakalidis, M.L.; Torres-Londoño, G.A.; Hausbeck, M. Population structure of a worldwide Phytophthora palmivora collection suggests lack of host specificity and reduced genetic diversity in South American and Caribbean. Plant Dis. 2021. [Google Scholar] [CrossRef]
- Mammella, M.A.; Martin, F.N.; Cacciola, S.O.; Coffey, M.D.; Faedda, R.; Schena, L. Analyses of the population structure in a global collection of Phytophthora nicotianae isolates inferred from mitochondrial and nuclear DNA sequences. Phytopathology 2013, 103, 610–622. [Google Scholar] [CrossRef] [PubMed] [Green Version]
- Prigigallo, M.I.; Mosca, S.; Cacciola, S.O.; Cooke, D.E.L.; Schena, L. Molecular analysis of Phytophthora diversity in nursery-grown ornamental and fruit plants. Plant Pathol. 2015, 64, 1308–1319. [Google Scholar] [CrossRef] [Green Version]
- Mehrotra, M.D. Diseases of Paulownia and their management. Indian For. 1997, 123, 66–72. [Google Scholar]
- Phytophthora Root Rot Plant List. RHS Gardening Advise. September 2020. Available online: https://www.rhs.org.uk/advice/pdfs/phytophthora-host-list.pdf (accessed on 10 October 2021).
- Ministry for Primary Industries Standard 155.02.06. Importation of Nursery Stock. Available online: https://www.mpi.govt.nz/dmsdocument/1152-nursery-stock-import-health-standard (accessed on 10 October 2021).
- Quarantine Pests (Fungi) Declined Entry into Sudan = (Zero Tolerance). Available online: https://assets.ippc.int/static/media/files/reportingobligation/2016/09/25/Quarantined_and_non-Quarantined_pest_list_in_Sudan.pdf (accessed on 10 October 2021).
- Abad, Z.G.; Abad, J.A.; Cacciola, S.O.; Pane, A.; Faedda, R.; Moralejo, E.; Pérez-Sierra, A.; Abad-Campos, P.; Alva-rez-Bernaola, L.A.; Bakonyi, J.; et al. Phytophthora niederhauserii sp. nov., a polyphagous species associated with ornamentals, fruit trees and native plants in 13 countries. Mycologia 2014, 106, 431–447. [Google Scholar] [CrossRef] [PubMed]
- Jung, T.; Orlikowski, L.; Henricot, B.; Abad-Campos, P.; Aday, A.G.; Aguín Casal, O.; Bakonyi, J.; Cacciola, S.O.; Cech, T.; Chavarriaga, D.; et al. Widespread Phytophthora infestations in European nurseries put forest, semi-natural and horticultural ecosystems at high risk of Phytophthora diseases. For. Pathol. 2016, 46, 134–163. [Google Scholar] [CrossRef] [Green Version]
- Garbelotto, M.; Frankel, S.J.; Scanu, B. Soil- and waterborne Phytophthora species linked to recent outbreaks in Northern California restoration sites. Calif. Agric. 2018, 72, 208–216. [Google Scholar] [CrossRef] [Green Version]
- Simamora, A.V.; Paap, T.; Howard, K.; Stukely, M.J.C.; Hardy, G.E.S.J.; Burgess, T.I. Phytophthora contamination in a nursery and its potential dispersal into the natural environment. Plant Dis. 2018, 102, 132–139. [Google Scholar] [CrossRef] [Green Version]
- Sims, L.; Tjosvold, S.; Chambers, D.; Garbelotto, M. Control of Phytophthora species in plant stock for habitat restoration through best management practices. Plant Pathol. 2019, 68, 196–204. [Google Scholar] [CrossRef] [Green Version]
- Sims, L.L.; Chee, C.; Bourret, T.; Hunter, S.; Garbelotto, M. Genetic and phenotypic variation of Phytophthora crassamura isolates from California nurseries and restoration sites. Fungal Biol. 2019, 123, 159–169. [Google Scholar] [CrossRef]
- Hong, C.X.; Gallegly, M.E.; Richardson, P.A.; Kong, P.; Moorman, G.V.; Lea-Cox, J.D.; Ross, D.S. Phytophthora hydropathica, a new pathogen identified from irrigation water, Rodhodendron catawbiense and Kalmia latifolia. Plant Pathol. 2010, 19, 913–921. [Google Scholar] [CrossRef]
- Loyd, A.; Benson, D.M.; Ivors, K.L. Phytophthora populations in nursery irrigation water in relationships to pathogenicity and infection frequency of rhododendron and pieris. Plant Dis. 2014, 98, 1213–1220. [Google Scholar] [CrossRef] [Green Version]

| Isolate Code | Phytophthora Taxa | Source | Accession Number |
|---|---|---|---|
| ITS | |||
| P4K1C7 | Ph. nicotianae | Bark | OK463579 |
| P4K3A3 | Ph. nicotianae | Bark | OK463580 |
| P1K2B2 | Ph. nicotianae | Bark | OK463581 |
| P4K1B6 | Ph. nicotianae | Bark | OK463582 |
| P1K6B6 | Ph. nicotianae | Bark | OK463583 |
| P4K3F8 | Ph. nicotianae | Bark | OK463584 |
| P1K4A3 | Ph. nicotianae | Bark | OK463585 |
| P3K4A9 | Ph. palmivora | Bark | OK463586 |
| P3K1B6 | Ph. palmivora | Bark | OK463587 |
| P3K4B10 | Ph. palmivora | Bark | OK463588 |
| C1K9E | Ph. nicotianae | Rhizosphere soil | OK463589 |
| C1K3F | Ph. nicotianae | Rhizosphere soil | OK463590 |
| C3K5A | Ph. nicotianae | Rhizosphere soil | OK463591 |
| C3Q5A | Ph. nicotianae | Rhizosphere soil | OK463592 |
| C3Q2B | Ph. nicotianae | Rhizosphere soil | OK463593 |
| C5K2C | Ph. nicotianae | Rhizosphere soil | OK463594 |
| C5K9D | Ph. nicotianae | Rhizosphere soil | OK463595 |
| C5Q2A | Ph. nicotianae | Rhizosphere soil | OK463596 |
| C6Q1A | Ph. nicotianae | Rhizosphere soil | OK463597 |
| C6K2E | Ph. nicotianae | Rhizosphere soil | OK463598 |
| CP1F | Ph. palmivora | Roots | OK463599 |
| CP2H | Ph. palmivora | Roots | OK463600 |
| CP2A | Ph. palmivora | Roots | OK463601 |
| CP2G | Ph. palmivora | Roots | OK463602 |
| CP1H | Ph. palmivora | Roots | OK463603 |
| CP1G | Ph. palmivora | Roots | OK463604 |
| CP2D | Ph. palmivora | Roots | OK463605 |
| CP2F | Ph. palmivora | Roots | OK463606 |
| CP2E | Ph. palmivora | Roots | OK463607 |
| CP2B | Ph. palmivora | Roots | OK463608 |
| CP1E | Ph. palmivora | Roots | OK463609 |
| CP2C | Ph. palmivora | Roots | OK463610 |
| C1K5A | Ph. palmivora | Rhizosphere soil | OK463611 |
| C1K4B | Ph. palmivora | Rhizosphere soil | OK463612 |
| C1K7A | Ph. palmivora | Rhizosphere soil | OK463613 |
| C2K3A | Ph. palmivora | Rhizosphere soil | OK463614 |
| C2K5B | Ph. palmivora | Rhizosphere soil | OK463615 |
| C2K4E | Ph. palmivora | Rhizosphere soil | OK463616 |
| C5K3A | Ph. palmivora | Rhizosphere soil | OK463617 |
| C5K4D | Ph. palmivora | Rhizosphere soil | OK463618 |
| C5Q2E | Ph. palmivora | Rhizosphere soil | OK463619 |
Publisher’s Note: MDPI stays neutral with regard to jurisdictional claims in published maps and institutional affiliations. |
© 2021 by the authors. Licensee MDPI, Basel, Switzerland. This article is an open access article distributed under the terms and conditions of the Creative Commons Attribution (CC BY) license (https://creativecommons.org/licenses/by/4.0/).
Share and Cite
Aloi, F.; Riolo, M.; La Spada, F.; Bentivenga, G.; Moricca, S.; Santilli, E.; Pane, A.; Faedda, R.; Cacciola, S.O. Phytophthora Root and Collar Rot of Paulownia, a New Disease for Europe. Forests 2021, 12, 1664. https://doi.org/10.3390/f12121664
Aloi F, Riolo M, La Spada F, Bentivenga G, Moricca S, Santilli E, Pane A, Faedda R, Cacciola SO. Phytophthora Root and Collar Rot of Paulownia, a New Disease for Europe. Forests. 2021; 12(12):1664. https://doi.org/10.3390/f12121664
Chicago/Turabian StyleAloi, Francesco, Mario Riolo, Federico La Spada, Gaetano Bentivenga, Salvatore Moricca, Elena Santilli, Antonella Pane, Roberto Faedda, and Santa Olga Cacciola. 2021. "Phytophthora Root and Collar Rot of Paulownia, a New Disease for Europe" Forests 12, no. 12: 1664. https://doi.org/10.3390/f12121664
APA StyleAloi, F., Riolo, M., La Spada, F., Bentivenga, G., Moricca, S., Santilli, E., Pane, A., Faedda, R., & Cacciola, S. O. (2021). Phytophthora Root and Collar Rot of Paulownia, a New Disease for Europe. Forests, 12(12), 1664. https://doi.org/10.3390/f12121664









